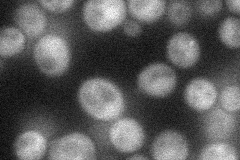
YDL037C
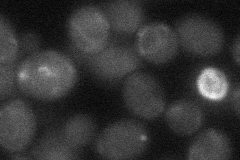
YDL037C
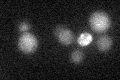
YDL037C

View description
Protein of unconfirmed function, similar to cell surface flocculin Muc1p; ORF exhibits genomic organization compatible with a translational readthrough-dependent mode of expression
Localization:
Intensity:
Fold change:
Significance:
-
C’ GFP library in SD

below threshold15.99 -
N' NOP1pr-GFP in SD
cytosol39.3466 -
N' TEF2pr-mCherry in SD

below threshold12.0763 -
N' NATIVEpr-GFP in SD

below threshold18.9332 -
N' TEF2pr-VC and Cyto-VN in SD
below threshold23.5286 -
C’ GFP library in SD+DTT

cytosol17.721.1No -
C’ GFP library in SD+H2O2

cytosol16.71.04No -
C’ GFP library in Starvation Media
cytosol18.21.13No -
C’ GFP library on the background of Pup2-DaMP

below threshold -
C’ GFP library on the background of CCT mutant

below threshold16.74821.04664No
